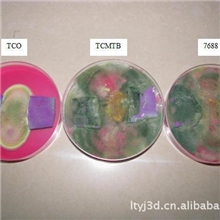
高效蓝皮防霉剂TCO，皮革防霉剂

刘群辉
主营:日化防腐剂/工业防腐剂;天然防腐剂/KPT;活化过氧化氢消毒剂;有机银抗菌剂;高效洗涤防腐剂;祛屑防腐剂;全效防腐防霉剂;高效防腐防霉剂;塑料防腐剂;高聚物乳液防腐剂;水处理杀菌剂/造纸杀菌剂;皮革防霉剂/塑料防腐剂;海洋油漆防霉剂;涂料防霉剂/胶粘剂防腐剂;高效洗涤防腐剂;卡松/凯松;杰马液(加强版);DMDMH/尼泊金酯;竹木板材防腐防霉剂;天然防敏剂/祛痘浓缩液
主营:日化防腐剂/工业防腐剂;天然防腐剂/KPT;活化过氧化氢消毒剂;有机银抗菌剂;高效洗涤防腐剂;祛屑防腐剂;全效防腐防霉剂;高效防腐防霉剂;塑料防腐剂;高聚物乳液防腐剂;水处理杀菌剂/造纸杀菌剂;皮革防霉剂/塑料防腐剂;海洋油漆防霉剂;涂料防霉剂/胶粘剂防腐剂;高效洗涤防腐剂;卡松/凯松;杰马液(加强版);DMDMH/尼泊金酯;竹木板材防腐防霉剂;天然防敏剂/祛痘浓缩液